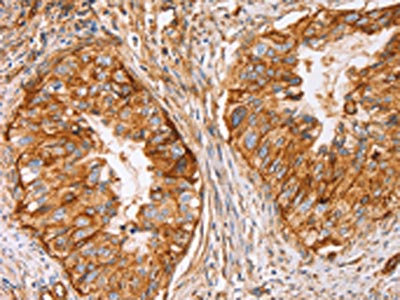

CD59 Antibody
-
中文名稱:CD59兔多克隆抗體
-
貨號:CSB-PA778176
-
規(guī)格:¥1100
-
圖片:
-
The image on the left is immunohistochemistry of paraffin-embedded Human thyroid cancer tissue using CSB-PA778176(CD59 Antibody) at dilution 1/50, on the right is treated with synthetic peptide. (Original magnification: ×200)
-
The image on the left is immunohistochemistry of paraffin-embedded Human cervical cancer tissue using CSB-PA778176(CD59 Antibody) at dilution 1/50, on the right is treated with synthetic peptide. (Original magnification: ×200)
-
Gel: 10%SDS-PAGE, Lysate: 40 μg, Lane 1-3: Huvec cells, hela cells, SKOV3 cells, Primary antibody: CSB-PA778176(CD59 Antibody) at dilution 1/500, Secondary antibody: Goat anti rabbit IgG at 1/8000 dilution, Exposure time: 30 seconds
-
-
其他:
產品詳情
-
Uniprot No.:
-
基因名:
-
別名:16.3A5 antibody; 1F5 antibody; 1F5 antigen antibody; 20 kDa homologous restriction factor antibody; CD 59 antibody; CD_antigen=CD59 antibody; CD59 antibody; CD59 antigen antibody; CD59 antigen complement regulatory protein antibody; CD59 antigen p18 20 antibody; CD59 antigen p18-20 (antigen identified by monoclonal antibodies 16.3A5; EJ16; EJ30; EL32 and G344) antibody; CD59 glycoprotein antibody; CD59 molecule antibody; CD59 molecule complement regulatory protein antibody; CD59_HUMAN antibody; Cd59a antibody; Complement regulatory protein antibody; EJ16 antibody; EJ30 antibody; EL32 antibody; FLJ38134 antibody; FLJ92039 antibody; G344 antibody; HRF 20 antibody; HRF-20 antibody; HRF20 antibody; Human leukocyte antigen MIC11 antibody; Ly 6 like protein antibody; Lymphocytic antigen CD59/MEM43 antibody; MAC inhibitory protein antibody; MAC IP antibody; MAC-inhibitory protein antibody; MAC-IP antibody; MACIF antibody; MACIP antibody; MEM43 antibody; MEM43 antigen antibody; Membrane attack complex (MAC) inhibition factor antibody; Membrane attack complex inhibition factor antibody; Membrane inhibitor of reactive lysis antibody; MGC2354 antibody; MIC11 antibody; MIN1 antibody; MIN2 antibody; MIN3 antibody; MIRL antibody; MSK21 antibody; p18 20 antibody; Protectin antibody; Surface antigen recognized by monoclonal antibody 16.3A5 antibody; T cell activating protein antibody
-
宿主:Rabbit
-
反應種屬:Human
-
免疫原:Synthetic peptide of Human CD59
-
免疫原種屬:Homo sapiens (Human)
-
標記方式:Non-conjugated
-
抗體亞型:IgG
-
純化方式:Antigen affinity purification
-
濃度:It differs from different batches. Please contact us to confirm it.
-
保存緩沖液:-20°C, pH7.4 PBS, 0.05% NaN3, 40% Glycerol
-
產品提供形式:Liquid
-
應用范圍:ELISA,WB,IHC
-
推薦稀釋比:
Application Recommended Dilution ELISA 1:2000-1:10000 WB 1:500-1:2000 IHC 1:100-1:300 -
Protocols:
-
儲存條件:Upon receipt, store at -20°C or -80°C. Avoid repeated freeze.
-
貨期:Basically, we can dispatch the products out in 1-3 working days after receiving your orders. Delivery time maybe differs from different purchasing way or location, please kindly consult your local distributors for specific delivery time.
-
用途:For Research Use Only. Not for use in diagnostic or therapeutic procedures.
相關產品
靶點詳情
-
功能:Potent inhibitor of the complement membrane attack complex (MAC) action. Acts by binding to the C8 and/or C9 complements of the assembling MAC, thereby preventing incorporation of the multiple copies of C9 required for complete formation of the osmolytic pore. This inhibitor appears to be species-specific. Involved in signal transduction for T-cell activation complexed to a protein tyrosine kinase.; The soluble form from urine retains its specific complement binding activity, but exhibits greatly reduced ability to inhibit MAC assembly on cell membranes.
-
基因功能參考文獻:
- Parainfluenza Virus 5 (PIV5) containing CD59 antigens (PIV5-CD59) shows increased resistance to complement-mediated neutralization in vitro comparing to PIV5 lacking regulators. Infection of A549 cells with PIV5 upregulates CD59 expression. TGF-beta treatment of PIV5-infected cells also increases cell surface CD59 expression and progeny virions are more resistant to complement-mediated neutralization. PMID: 29693588
- Nonfunctioning CD59 is a major risk factor for stroke and hypercoagulability. PMID: 29929138
- Therapeutic strategies that seek to modulate the functions of CD59 in the tumor microenvironment could be a promising direction for tumor immunotherapy. PMID: 29521526
- This study demonstrated that Diffuse microvascular C5b-9 deposition is a common feature in muscle and nerve biopsies from diabetic patients. PMID: 29458425
- Movement of Domain 2 with respect to Domain 3 of ILY is essential for forming a late prepore intermediate that releases CD59, while the role of cholesterol may be limited to insertion of the transmembrane segments. Together these data define a structural timeline for ILY pore formation and suggest a mechanism that is relevant to understanding other pore-forming toxins that also require CD59. PMID: 27910935
- CD59 polymorphisms are associated with gene expression and different sexual susceptibility to pemphigus foliaceus in the Brazilian patients. PMID: 28534443
- we demonstrated that CD59 regulation by SOX2 is required for stem cell evasion of complement surveillance. This finding highlights the importance of complement surveillance in eliminating CSCs and may suggest CD59 as a potential target for cancer therapy. PMID: 28017655
- The results indicate that shear stress is an important mediator in endothelial progenitor cells expression of CD59 regulated by the extacellular matrix-integrin alphaVbeta3-F-actin pathway, which is a key factor in preventing membrane attack complex-mediated cell autolysis. PMID: 28943429
- Data show that following 4 patients with CD59 Cys89Tyr mutations who are treated with eculizumab, no strokes occurred and non-permanent neurological insults underwent resolution without any new neurological exacerbations. PMID: 28622911
- our results indicate that the Lys(41) /His(44) glycation motif in human CD59 may confer humans a higher risk of developing vascular disease in response to hyperglycemia. PMID: 28815695
- Structural basis for receptor recognition by the human CD59-responsive cholesterol-dependent cytolysins has been presented. PMID: 27499440
- developed a model of conditional and targeted cell ablation by generating floxed STOP-CD59 knockin mice (ihCD59), in which expression of human CD59 only occurs after Cre-mediated recombination PMID: 27159394
- Our results revealed that SNPs CD59-rs831626 and CFH-rs1065489 were associated with the susceptibility of acute anterior uveitis. PMID: 27419833
- Novel disorder caused by CD59 deficiency or nonfunctional CD59 at the cell membrane presenting with symptoms characteristic of classical GBS or CIDP. PMID: 27568864
- Single-fluorescent-molecule imaging in the live-cell plasma membrane revealed the clear but transient colocalization and codiffusion of fluorescent ganglioside analogs with a fluorescently labeled glycosylphosphatidylinisotol (GPI)-anchored protein, human CD59, with lifetimes of 12 ms for CD59 monomers, 40 ms for CD59's transient homodimer rafts in quiescent cells. PMID: 27043189
- There is an altered pattern of CD55 and CD59 expression on RBCs of SCD Patients; however, it does not seem to play a causal role in the pathophysiology of anemia, and is unlikely to be influenced by the level of erythropoietin or other inflammatory mediators. PMID: 27667587
- Study revealed that CD59 is overexpressed in breast cancer tumors and correlates with poor survival. PMID: 26935178
- A Promoter Polymorphism in the CD59 Gene in Donor Lungs Correlates With a Higher Risk for Chronic Rejection After Lung Transplantation. PMID: 26517734
- Urinary CD59 and alpha-1 antitrypsin are significantly altered in hypertensive patients developing albuminuria. PMID: 26772976
- levels of CSF CD59 in neuromyelitis optica and multiple sclerosis PMID: 26686775
- Increased internalization of endothelial CD59 in intermittent hypoxia appeared to be cholesterol-dependent and was reversed by statins in a CD59-dependent manner. PMID: 26738794
- Low urine CD59 expression is associated with clear cell renal cell carcinoma. PMID: 26420021
- Decreased CD59 expression in threatened miscarriage at late gestational ages leads to additional activation of a maternal immune response and serves as a possible predictor for premature birth. PMID: 26978230
- Data show that the palmitoylation mutation of linker for activation of T cells (LAT)attenuated the signal transduction induced by glycosylphosphatidylinositol-anchored CD59 antigen in T cells. PMID: 26271970
- After blockage of CD59 function, the reactive Abs, regardless of their neutralizing activities, significantly enhanced specific ADCML of HIV-1 virions PMID: 26136568
- Genetic risk at the CFH-to-F13B locus was associated with higher levels of complement activation at the human macular RPE-choroid interface, as was cigarette smoking. Levels of CRP were substantially elevated in risk donors with smoking history. PMID: 26218915
- A primary homozygous Cys89Tyr CD59 deficiency in humans resulted in the amino acid substitution p.Cys89Tyr with ensuing failure of proper localization of the CD59 protein to the cell surface. (Review) PMID: 25818314
- Increased CD59 protein expression is associated with the outcome of patients with diffuse large B-cell lymphoma treated with R-CHOP antineoplastic protocol. PMID: 24924474
- Data suggest that microRNA-224 directly down-regulates CD59 antigen expression in diffuse large B-cell lymphoma by binding to CD59 3'-untranslated region. PMID: 25146331
- Expression of membrane complement regulators, CD46, CD55 and CD59, in mesothelial cells of patients on peritoneal dialysis therapy. PMID: 25725314
- The presence of CD55- and/or CD59-deficient erythrocytic populations in patients with rheumatic diseases reflects an immune-mediated bone-marrow derived phenomenon. PMID: 24463881
- Provirus activation plus CD59 blockage triggers antibody-dependent complement-mediated lysis of latently HIV-1-infected cells. PMID: 25149467
- Data indicate that down-regulation of CD59 expression could inhibit HeLa cells' proliferation and promote apoptosis, and the inhibitory effect of peptide seal was better than that of CD59 interference plasmid. PMID: 24909278
- The expression levels of CD46, CD55, and CD59 were significantly higher in colon cancer tissues compared with the normal adjacent colon tissues. PMID: 24978917
- this study observed robust relationships between a single measurement of blood levels of GCD59 and both acute (2-hour OGTT) and chronic (HbA1c) measures of glucose handling. PMID: 24628556
- Hemolytic uremic syndrome evolved independently from CD55 and CD59 expression on peripheral blood cells in enteroaggregative E.coli O104:H4 infected patients. PMID: 24086391
- Data suggest that CD59 gene might be a genetic locus for the therapy of atherosclerosis. PMID: 24084445
- We found that CD46 and CD59 were decreased in retinal pigment epithelium cells in part, by their release in exosomes and apoptotic particles. PMID: 24664706
- Use of AAV2/8-sCD59 warrants further exploration as a potential therapy for advanced stages of diabetic retinopathy PMID: 24167638
- Sp1 may regulate the expression of CD59, whereas CREB-binding protein (CBP)/p300 bridge NF-kappaB and CREB, which functions as an enhancer-binding protein to induce the up-regulation of CD59 during in lipopolysaccharide (LPS)-triggered complement activation. PMID: 24338025
- CD59 silencing in NSCLC cancer cells via retrovirus-mediated RNAi can enhance complement-mediated cell apoptosis, inhibiting the growth of NSCLC. CD59 may serve as a potential target for gene therapy in NSCLC PMID: 23835643
- mutation of palmitoylation site of LAT-EGFP attenuated the signal transduction of CD59 in T cells PMID: 24200054
- The primary CD59-ILY binding site is composed of a side-to-side contact between the beta hairpin extension of ILY D4 and the core beta sheet of CD59. PMID: 23665225
- Data show that increased CD35, CD46, CD55 and CD59 on neutrophils and monocytes present potent markers of bacterial infection and viral infection. PMID: 23376460
- Hematology and diabetes: from hemoglobin A1c to CD59 glycation. PMID: 23757192
- a novel, sensitive, and specific ELISA for measuring GCD59 in blood. The assay distinguished individuals with diabetes from those without, and showed strong correlation between GCD59 and HbA1c. PMID: 23670858
- CD59 was a type of membrane-bound protein, CD59 and Cbp played synergistic roles in cell activation and proliferation. PMID: 23746236
- HCV incorporates selectively CD59, but not CD46 or CD55, in its envelope to gain resistance to CML in serum of infected individuals PMID: 23049856
- A Cys89Tyr mutation is associated with improper cell-surface localization of CD59. This mutation is manifested clinically in infancy by chronic hemolysis & relapsing peripheral demyelinating disease. PMID: 23149847
- findings demonstrated that decreased CD59 expression on T cells significantly enhanced activation and proliferation of CD4( ) T cells and CD8( ) T cells; data support that CD59 down-regulates antigen-specific activation of T lymphocytes in a ligand-dependent manner PMID: 22480874
顯示更多
收起更多
-
相關疾病:Hemolytic anemia, CD59-mediated, with or without polyneuropathy (HACD59)
-
亞細胞定位:Cell membrane; Lipid-anchor, GPI-anchor. Secreted. Note=Soluble form found in a number of tissues.
-
數(shù)據(jù)庫鏈接:
Most popular with customers
-
-
YWHAB Recombinant Monoclonal Antibody
Applications: ELISA, WB, IHC, IF, FC
Species Reactivity: Human, Mouse, Rat
-
Phospho-YAP1 (S127) Recombinant Monoclonal Antibody
Applications: ELISA, WB, IHC
Species Reactivity: Human
-
-
-
-
-